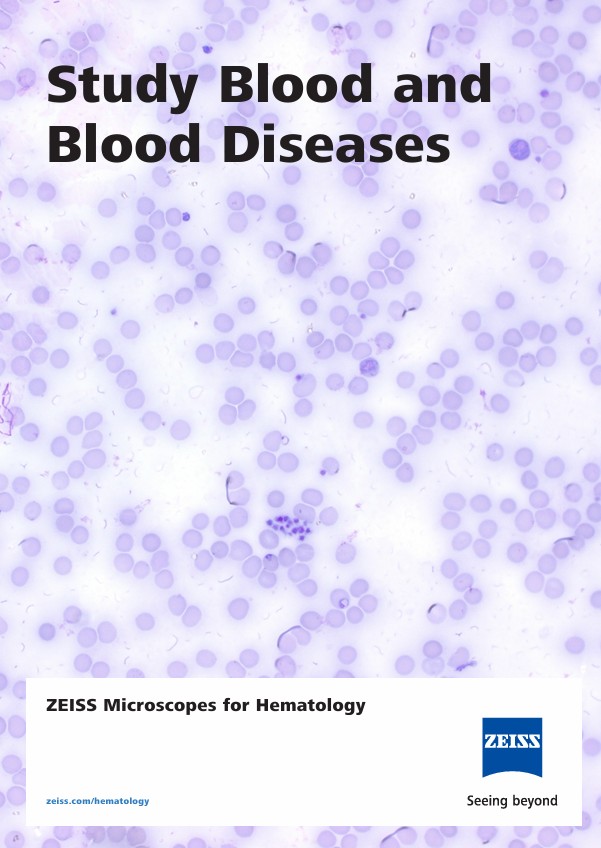
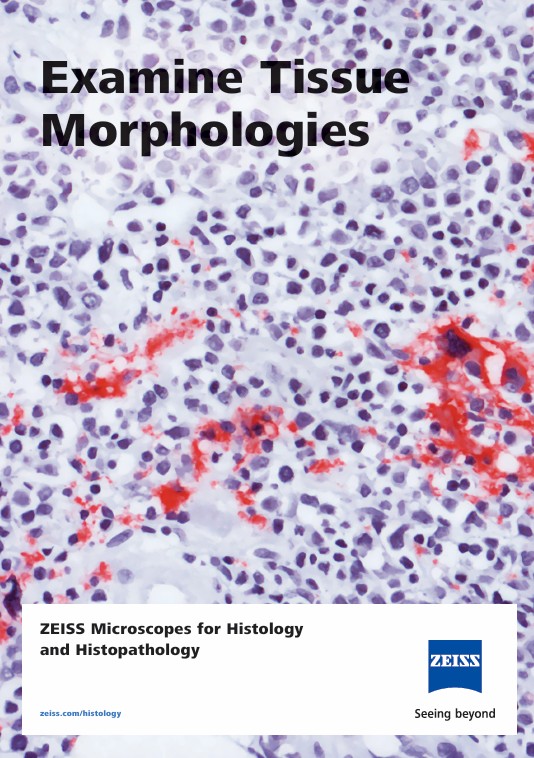

ZEISS Primostar 3 蔡司基礎型顯微鏡
數位教學與例行實驗室顯微鏡
無論您需要顯微鏡用於教育、訓練或例行實驗室工作:Primostar 3 是一款易於使用、體積小巧且耐用的儀器,能讓您的投資成為即使在空間有限環境中也能長時間工作的最佳選擇。
您的學生、受訓者和實驗室工作人員可以從一開始就專注於基本內容——只要從我們預先定義的套件中選擇最適合您任務與應用的顯微鏡配置,您就準備好了。Primostar 3 開箱即用,提供真正的即插即用體驗,成為您現今及未來顯微鏡的可靠夥伴。
相關應用
檔案下載
|
ZEISS Primostar 3→ |
ZEISS 細胞病理顯微鏡→ |
ZEISS 血液學顯微鏡→ |
ZEISS 組織學顯微鏡→ |
|
ZEISS Primostar 1→ |
ZEISS Primostar 3→ |
生物醫學實驗室用顯微鏡→ |
 |